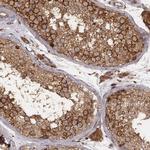
VPS26A Antibody in Immunohistochemistry (Paraffin) (IHC (P))

Search
Invitrogen
VPS26A Monoclonal Antibody (CL2287)
{{$productOrderCtrl.translations['antibody.pdp.commerceCard.promotion.promotions']}}
{{$productOrderCtrl.translations['antibody.pdp.commerceCard.promotion.viewpromo']}}
{{$productOrderCtrl.translations['antibody.pdp.commerceCard.promotion.promocode']}}: {{promo.promoCode}} {{promo.promoTitle}} {{promo.promoDescription}}. {{$productOrderCtrl.translations['antibody.pdp.commerceCard.promotion.learnmore']}}
图: 1 / 15
VPS26A Antibody (MA5-31365) in ICC/IF

产品信息
MA5-31365
种属反应
宿主/亚型
分类
类型
克隆号
偶联物
形式
浓度
规格
纯化类型
保存液
内含物
保存条件
运输条件
RRID
产品详细信息
Immunogen sequence: LRKQRTNFHQ RFESPESQAS AEQPEM
Highest antigen sequence indentity to the following orthologs: Mouse - 96%, Rat - 100%.
靶标信息
This gene belongs to a group of vacuolar protein sorting (VPS) genes. The encoded protein is a component of a large multimeric complex, termed the retromer complex, involved in retrograde transport of proteins from endosomes to the trans-Golgi network. The close structural similarity between the yeast and human proteins that make up this complex suggests a similarity in function. Expression studies in yeast and mammalian cells indicate that this protein interacts directly with VPS35, which serves as the core of the retromer complex. Alternative splicing results in multiple transcript variants encoding different isoforms.
仅用于科研。不用于诊断过程。未经明确授权不得转售。
篇参考文献 (0)
生物信息学
蛋白别名: FLJ12930; HB58; Hbeta58; Hbeta58 homolog; hVPS26; OTTHUMP00000019721; PEP8A; unnamed protein product; vacuolar protein sorting 26 homolog A; Vacuolar protein sorting-associated protein 26A; Vesicle protein sorting 26A; VPS26; VPS26 retromer complex comonent A
基因别名: HB58; Hbeta58; PEP8A; VPS26; VPS26A
UniProt ID: (Human) O75436
Entrez Gene ID: (Human) 9559




